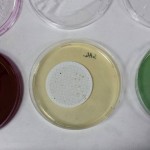

Lo squallido stato del sentiero dell’Ente Parco e l’inquinamento delle acque della sorgente superiore.
È di questi giorni la notizia che a Sant’Anastasia il sindaco Abete celebrerà con la cittadinanza i suoi primi sei mesi di governo. È auspicabile che saranno tutte rose e fiori e che gli eventuali intoppi saranno attribuibili alla contingenza, all’imprevedibile, all’imponderabile o a qualcun altro; sicuramente non a chi lo ha preceduto come andante e prassi politica invece vorrebbe.
A Sant’Anastasia le cose, come del resto in tutto il Vesuviano, non vanno granché bene e questo soprattutto dal punto di vista ambientale. Già in passato abbiamo potuto mostrare come anche la ridente cittadina fosse soggetta a scarichi e sversamenti illegali (link) e che la questione della sentieristica vesuviana era in uno stato pressoché pietoso; bene, o meglio, male! A sei mesi dall’insediamento del buon Abete, almeno da questo punto di vista, nulla è cambiato.
A parte la notizia del fermo di alcune persone, rigorosamente “non anastasiane”, che scaricavano rifiuti alla Zazzera nulla è successo e facendo una passeggiata lungo lo stradello di campagna e quello dell’Olivella ci si renderà conto, non solo che questo è inquinato ma che a farlo sono quasi sicuramente anche i locali. Certo, le “prove provate” non le abbiamo, esisterebbero le forze dell’ordine per questo ma se dessimo un’occhiata ai rifiuti capiremmo che, come succede altrove, questi rifiuti, sia essi speciali, sia essi pericolosi, domestici o industriali, quasi sempre vengono da vicino, molto vicino! Ma è ovvio che stanare o colpevolizzare un elettore non conviene a nessuno, per cui la colpa è sempre degli altri.
Tornando allo splendido percorso che conduce alle sorgenti dell’Olivella, il numero dieci dei sentieri del Parco Nazionale del Vesuvio, potremmo, percorrendolo, fare un corso sul rifiuto umano, c’è praticamente di tutto, dal frigorifero al mobile, dagli scarti edili a quelli agricoli e così via. In certi punti, in prossimità di scarpate si è pensato di occultare lo scarico lungo i pendii ma anche lungo la strada non mancano esempi di chi si disfa della propria immondizia in maniera più sbrigativa.
Giunti alle fonti se ne avverte la bellezza e il fascino che un tempo potevano emanare e proprio sotto la Madonnina, a segno anche dell’alta religiosità degli autoctoni, troviamo un mare di monnezza. In questo caso si tratta della solita abitudine del picnic sul prato, soprattutto per il mercoledì delle Ceneri (comprovato dalla data dei rifiuti trovati e riportanti ancora gli scontrini), Ma non manca chi, dopo aver pensato alla pancia, ha pensato anche ad altri organi e il tutto sempre sotto lo sguardo pietoso della Vergine Maria; ma ci sono pure i copertoni, il polistirolo e i sacconi di plastica, questi ultimi dalla chiara provenienza agricola.
Per terra scorgiamo parecchie cartucce che i cacciatori continuano a sparare in maniera indisturbata e il diserbante, nei fondi vicini, è usato a iosa, segno questo dell’attiva vigilanza del Corpo Forestale e di un Parco Nazionale sempre presenti.
Ma per fortuna c’è l’acqua, quella che col suo rinfrescante e riposante scroscio stilla dalle rocce vulcaniche, quella almeno è pulita. E invece no! La nostra inesauribile curiosità ci ha fatto indagare e siamo riusciti a far analizzare le acque della sorgente superiore e il risultato è che questa non è potabile. Infatti, oltre il fluoro superiore di 2,69 mg/L rispetto al già alto limite per le zone vulcaniche (1,5mg/L), abbiamo riscontrato la preoccupante presenza di coliformi fecali, escherichia coli, enterococchi e di clostridium perfrigens. L’acqua, così com’è, non è idonea al consumo umano perché contaminata da inquinamento fecale. I suddetti batteri non sono pericolosi in quanto tali perché potrebbero procurare solo una dissenteria ma possono esserlo in quanto indicatori della presenza di possibili parassiti, di salmonella, virus dell’epatite o altri batteri patogeni. Per cui, l’acqua della sorgente, per essere consumata andrebbe correttamente sottoposta a un processo di disinfezione.
Rimandiamo alle autorità preposte l’onere di indagare più a fondo sulla natura di tale contaminazione e se questa sia umana o animale ma soprattutto se sia giusto che un luogo così prezioso meriti lo stato d’abbandono riscontrato.